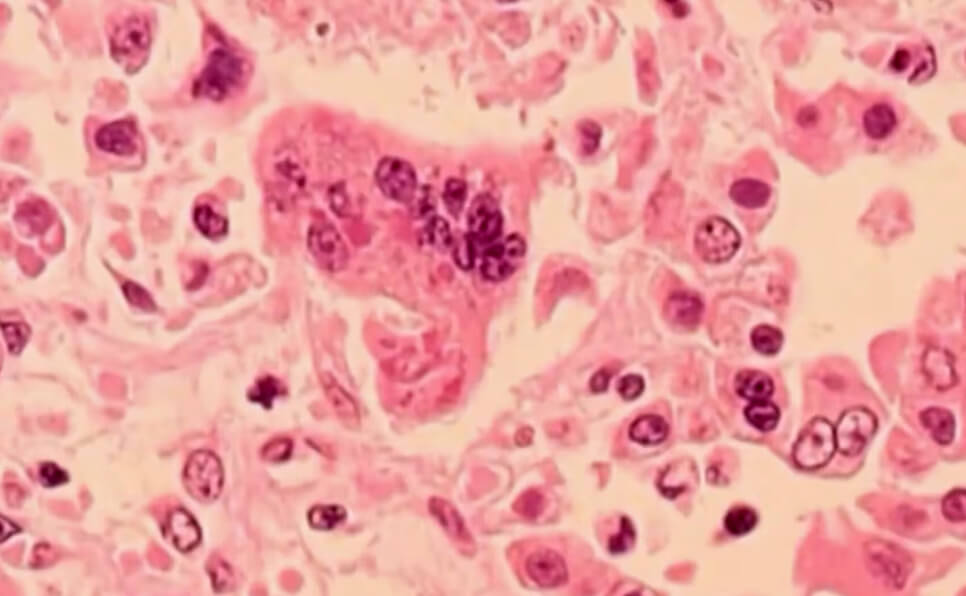

വിനിപെഗ് : നഗരത്തിലെ അഞ്ച് പുതിയ സ്ഥലങ്ങളിൽ കൂടി അഞ്ചാംപനി എക്സ്പോഷർ കണ്ടെത്തിയതായി മാനിറ്റോബ പൊതുജനാരോഗ്യ ഉദ്യോഗസ്ഥർ മുന്നറിയിപ്പ് നൽകി. നവംബർ 6 നും നവംബർ 12 നും ഇടയിലാണ് എക്സ്പോഷർ നടന്നത്.

എക്സ്പോഷർ സൈറ്റുകൾ :
- മൈനർ ഇൽനെസ് ആൻഡ് ഇൻജുറി ക്ലിനിക് (102-1001 കോറിഡൺ അവന്യൂ) നവംബർ 12 ന് ഉച്ചയ്ക്ക് 12:40 മുതൽ 3:30 വരെ.
- ലാൻഡ്മാർക്ക് സിനിമ (127-1120 ഗ്രാൻ്റ് അവന്യൂ) നവംബർ 8 ന് ഉച്ചയ്ക്ക് 5:45 മുതൽ നവംബർ 9 ന് പുലർച്ചെ 12:45 വരെ.
- സിഎഫ് പോളോ പാർക്ക് (1485 പോർട്ടേജ് അവന്യൂ) നവംബർ 7 ന് വൈകുന്നേരം 4:30 മുതൽ രാത്രി 8:30 വരെ.
- വൈഎംസിഎ വെസ്റ്റ് വുഡ് (3550 പോർട്ടേജ് അവന്യൂ) നവംബർ 6 ന് ഉച്ചയ്ക്ക് 2 മുതൽ വൈകുന്നേരം 7:15 വരെ.
- നകമുറ ജൂഡോ (439 മക്ഫിലിപ്സ് സ്ട്രീറ്റ്) നവംബർ 6 ന് വൈകുന്നേരം 7:45 മുതൽ രാത്രി 11:15 വരെ.
ഈ തീയതികളിലും സമയങ്ങളിലും ഈ സ്ഥലങ്ങളിൽ എത്തിയവർ രോഗലക്ഷണങ്ങൾ നിരീക്ഷിക്കുകയും അഞ്ചാംപനി വാക്സിൻ സ്വീകരിച്ചിട്ടുണ്ടോ എന്ന് പരിശോധിക്കണമെന്നും ആരോഗ്യവകുപ്പ് നിർദ്ദേശിച്ചു.